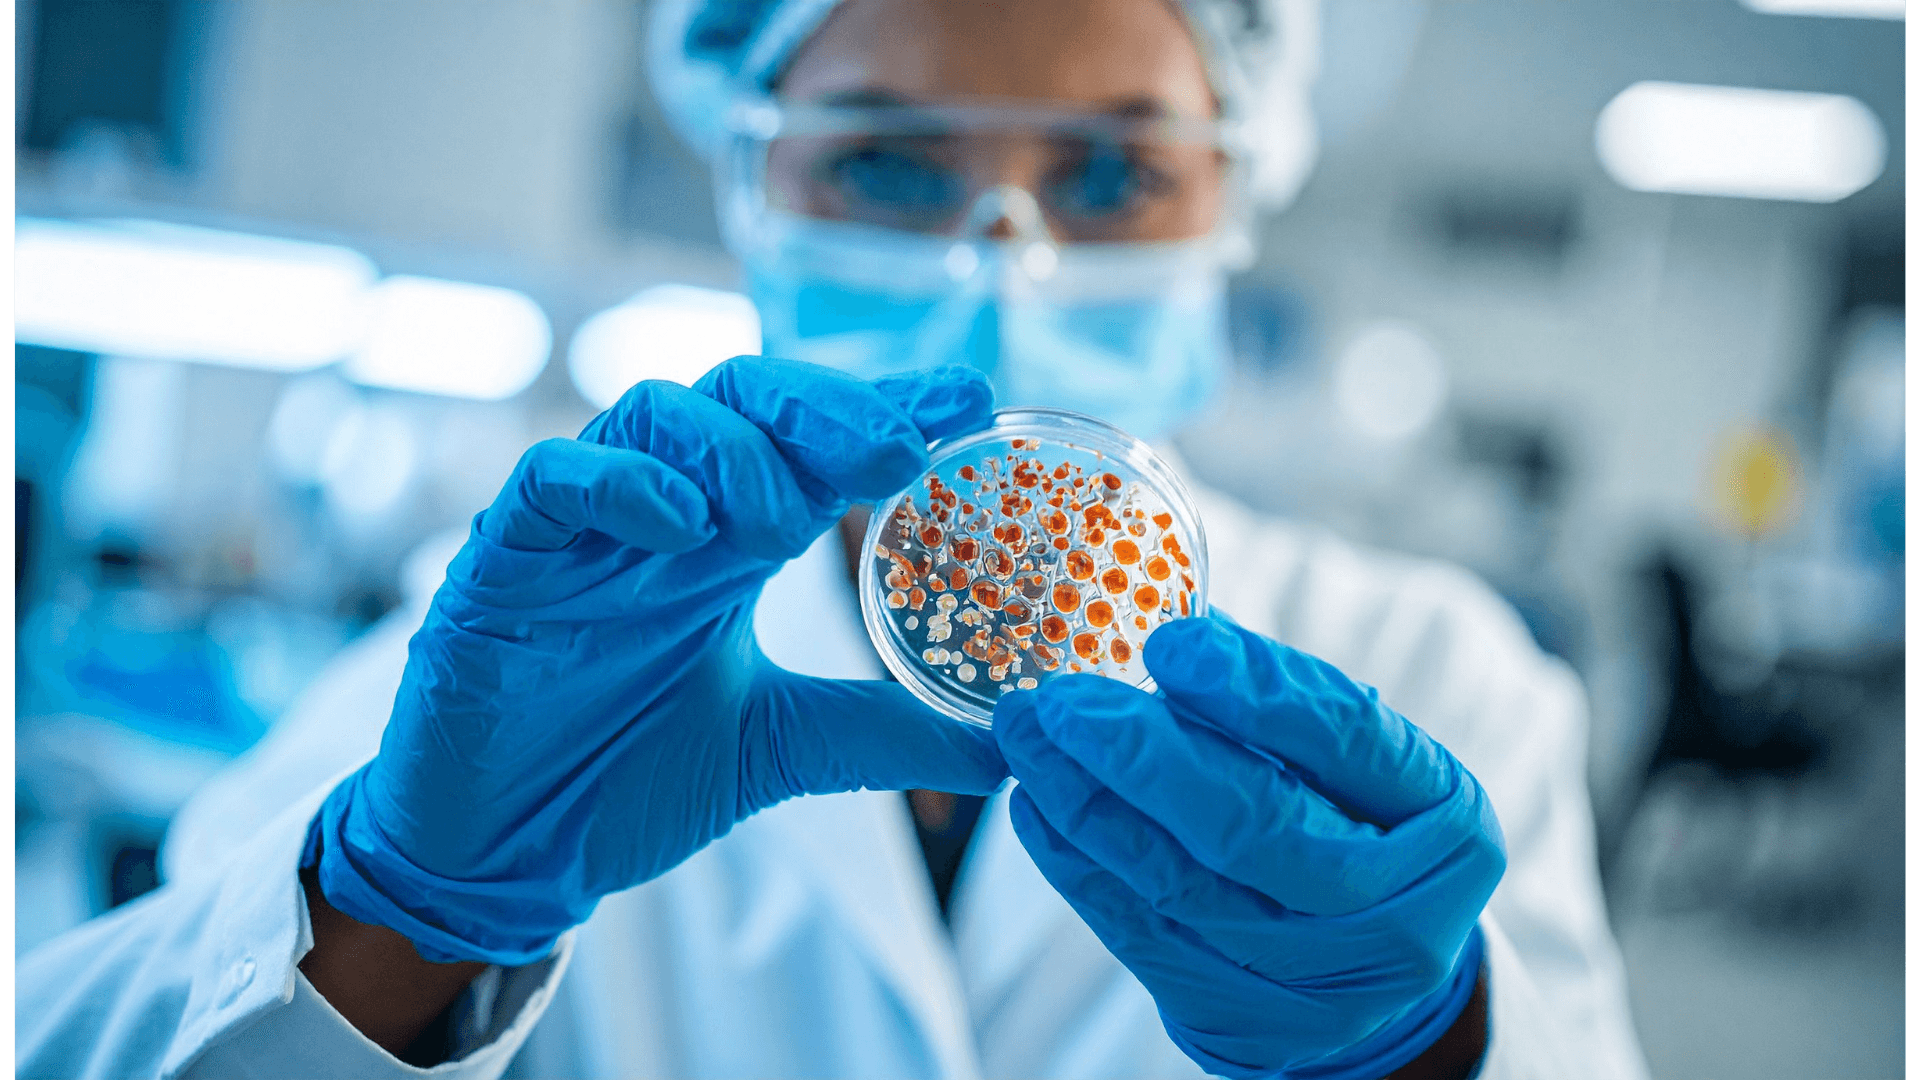
Scientists analyzing biological and disease data

Technical + Biological Specialists Working as a Team
Specialties
Our diverse team brings deep expertise to every challenge. If you have complex life science data problems to solve, our team can handle it.
We have the expertise to help
Deep technical and biological expertise across the full spectrum of life science data challenges.
Bioinformatics
Are you developing a new drug, a diagnostic test, or a bioactive compound that requires you to understand molecular mechanisms of action? Is your team about to take on a large NGS initiative without the right people to process and analyze the data at the other end?
...and more!

Statistics
Do you need to design and analyze a clinical trial or an experiment, or maybe you want to make sure your data is reliable and valid?
...and more!

Cloud Infrastructure
Do you want to store, access, and process your data on the cloud? Do you want a flexible, secure, and cost-effective cloud infrastructure? Do you want to avoid the hassle of managing your own data infrastructure?
...and more!

Machine Learning
Do you want to discover hidden patterns and insights from your data? Maybe you want to build models that can learn from data and make predictions, or optimize your solutions for complex problems?
...and more!

Artificial Intelligence
Do you want to create intelligent systems that can understand natural language, categorize images, or recognize genomic patterns? Do you want to explore what new possibilities intelligent systems can bring to your life science applications?
...and more!

Software Engineering
Do you need software applications for your life science projects? Do you want software solutions that are user-friendly, functional, and high-quality? Do you want to avoid the hassle of developing your own software applications?
...and more!
Service Provider Partnerships
Since we believe that collaboration is key to advancing discoveries and fostering innovation in the life sciences, we actively partner with a diverse range of companies and organizations to provide comprehensive solutions tailored to your specific needs.
Our network of trusted service providers expands our capabilities beyond our core expertise, allowing us to deliver holistic solutions that address the unique challenges you may encounter. Together with these esteemed partners, we strive to support your scientific aspirations and drive your projects toward success.
...and anyone else who can complement our team!
Making Actionable Insights Happen Faster
Ready to tackle your next data challenge? Schedule a quick call to discuss how our specialties can accelerate your research.